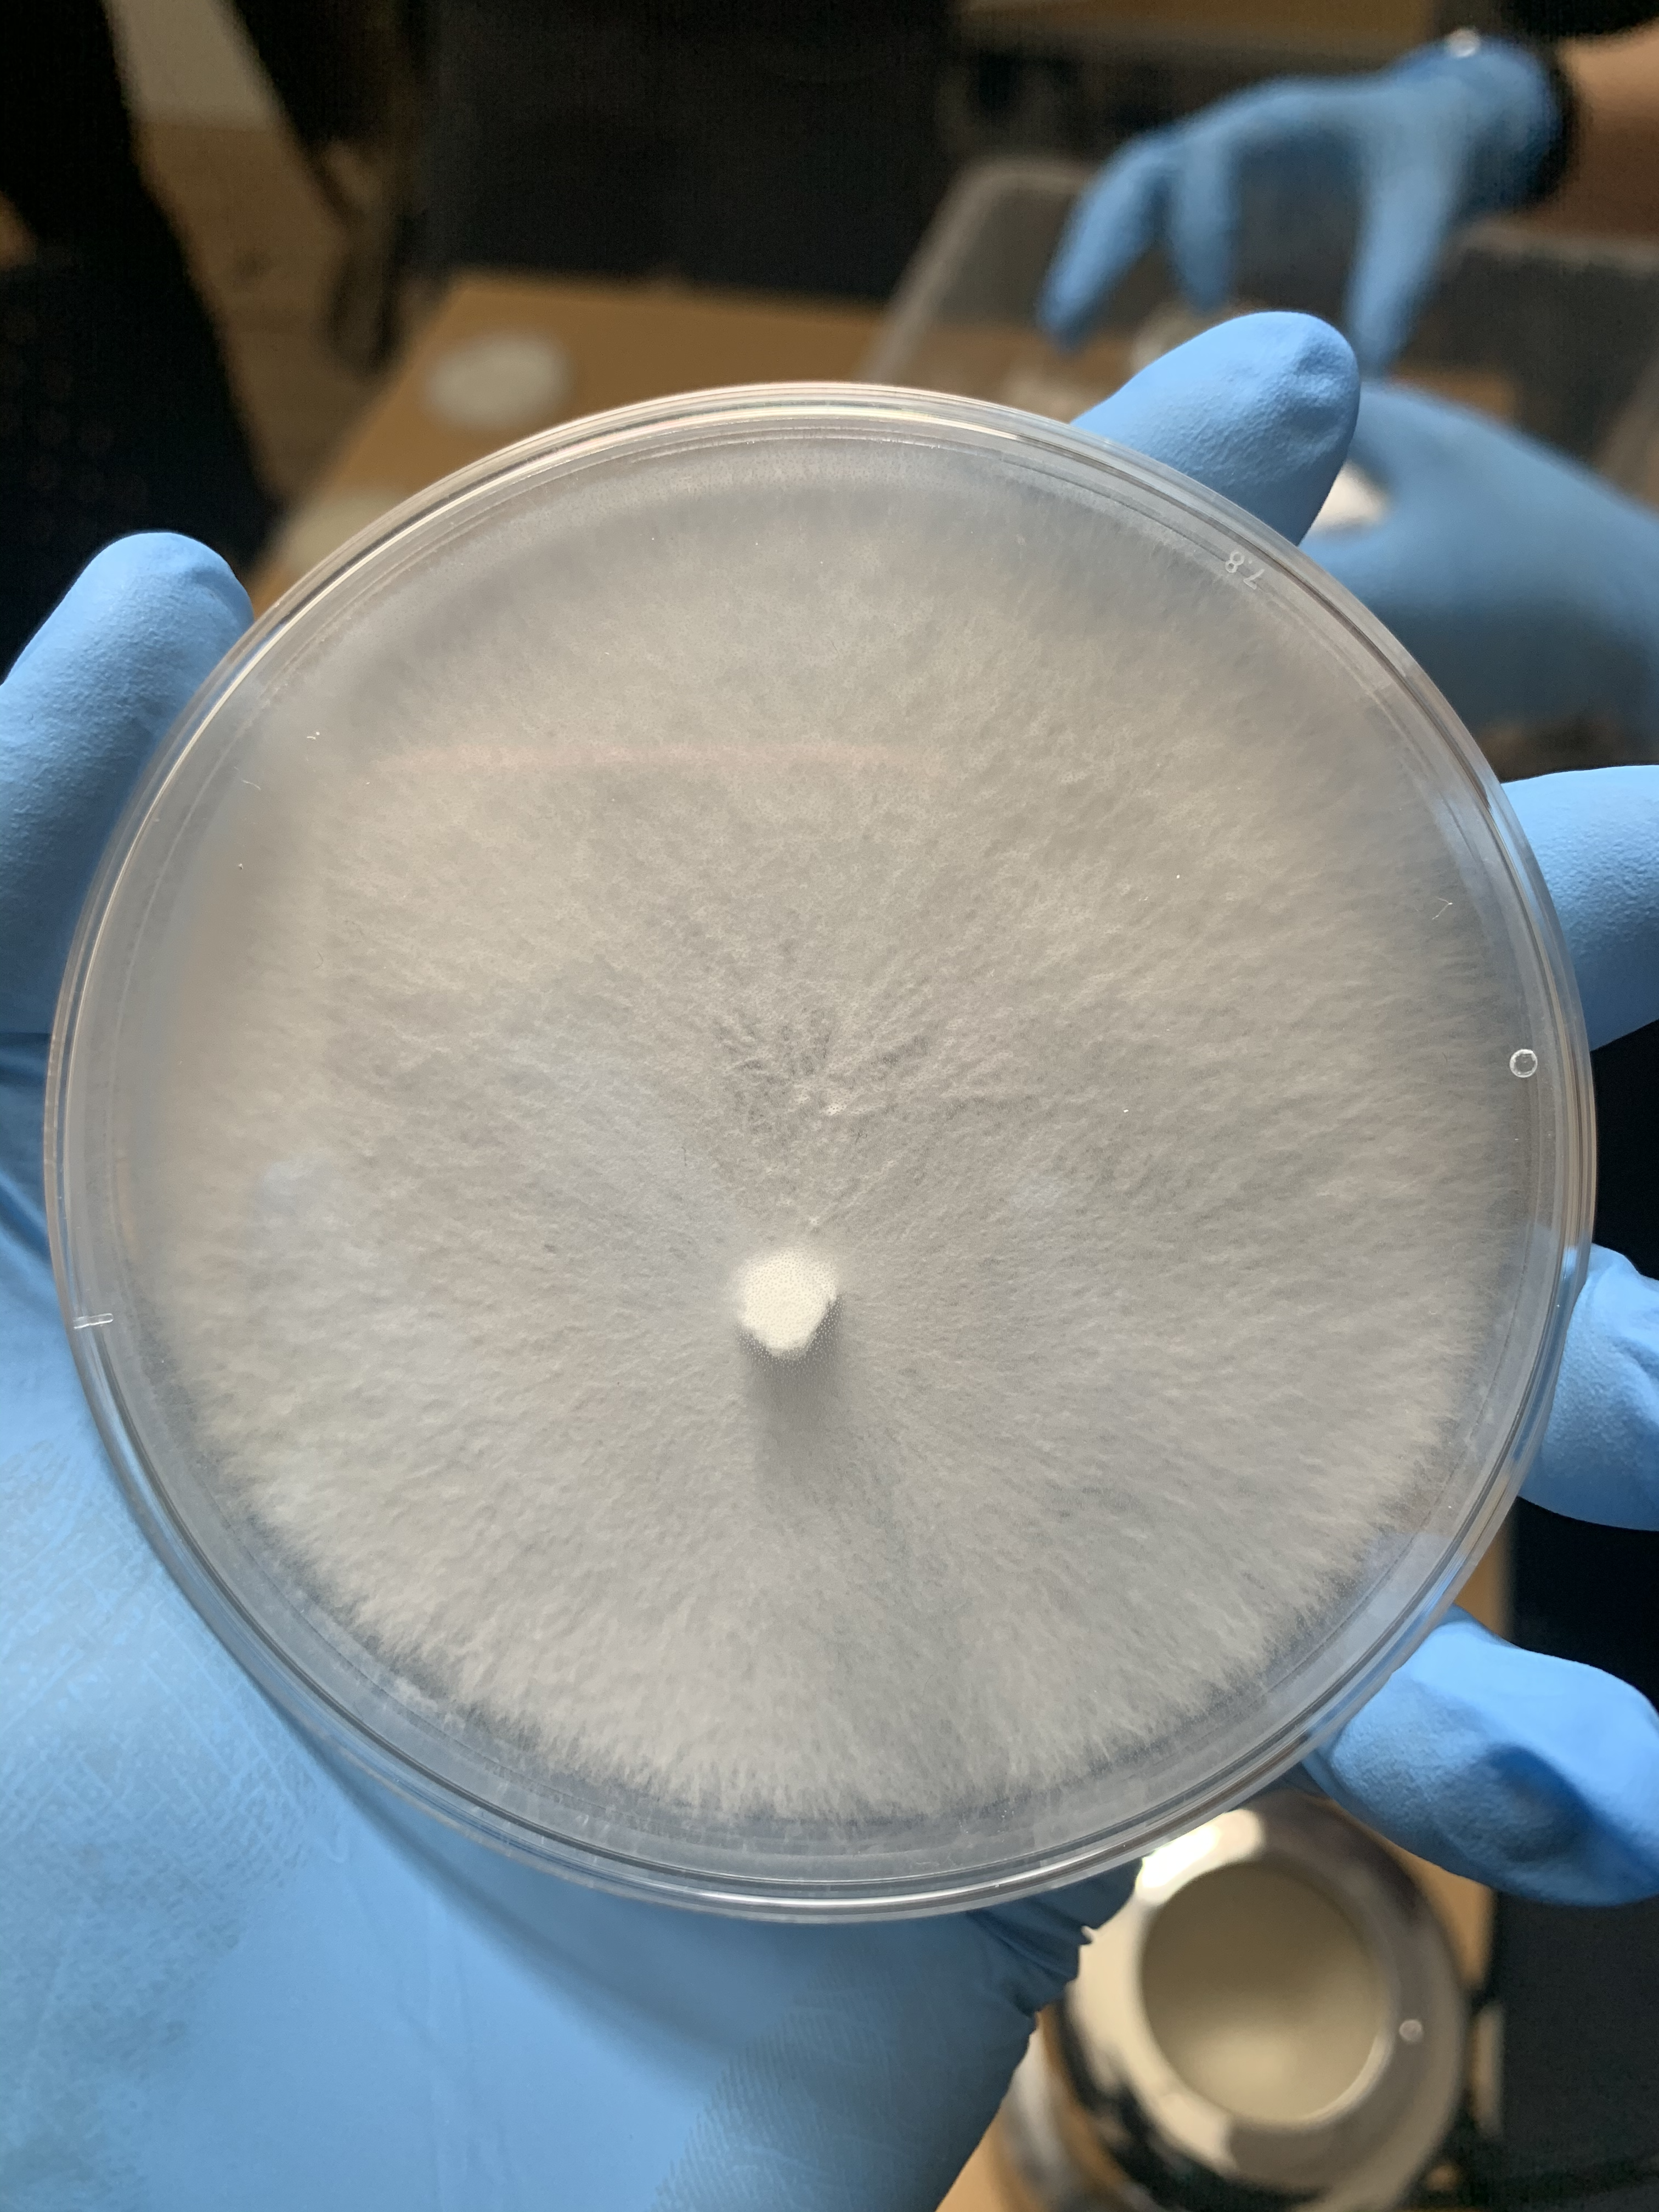
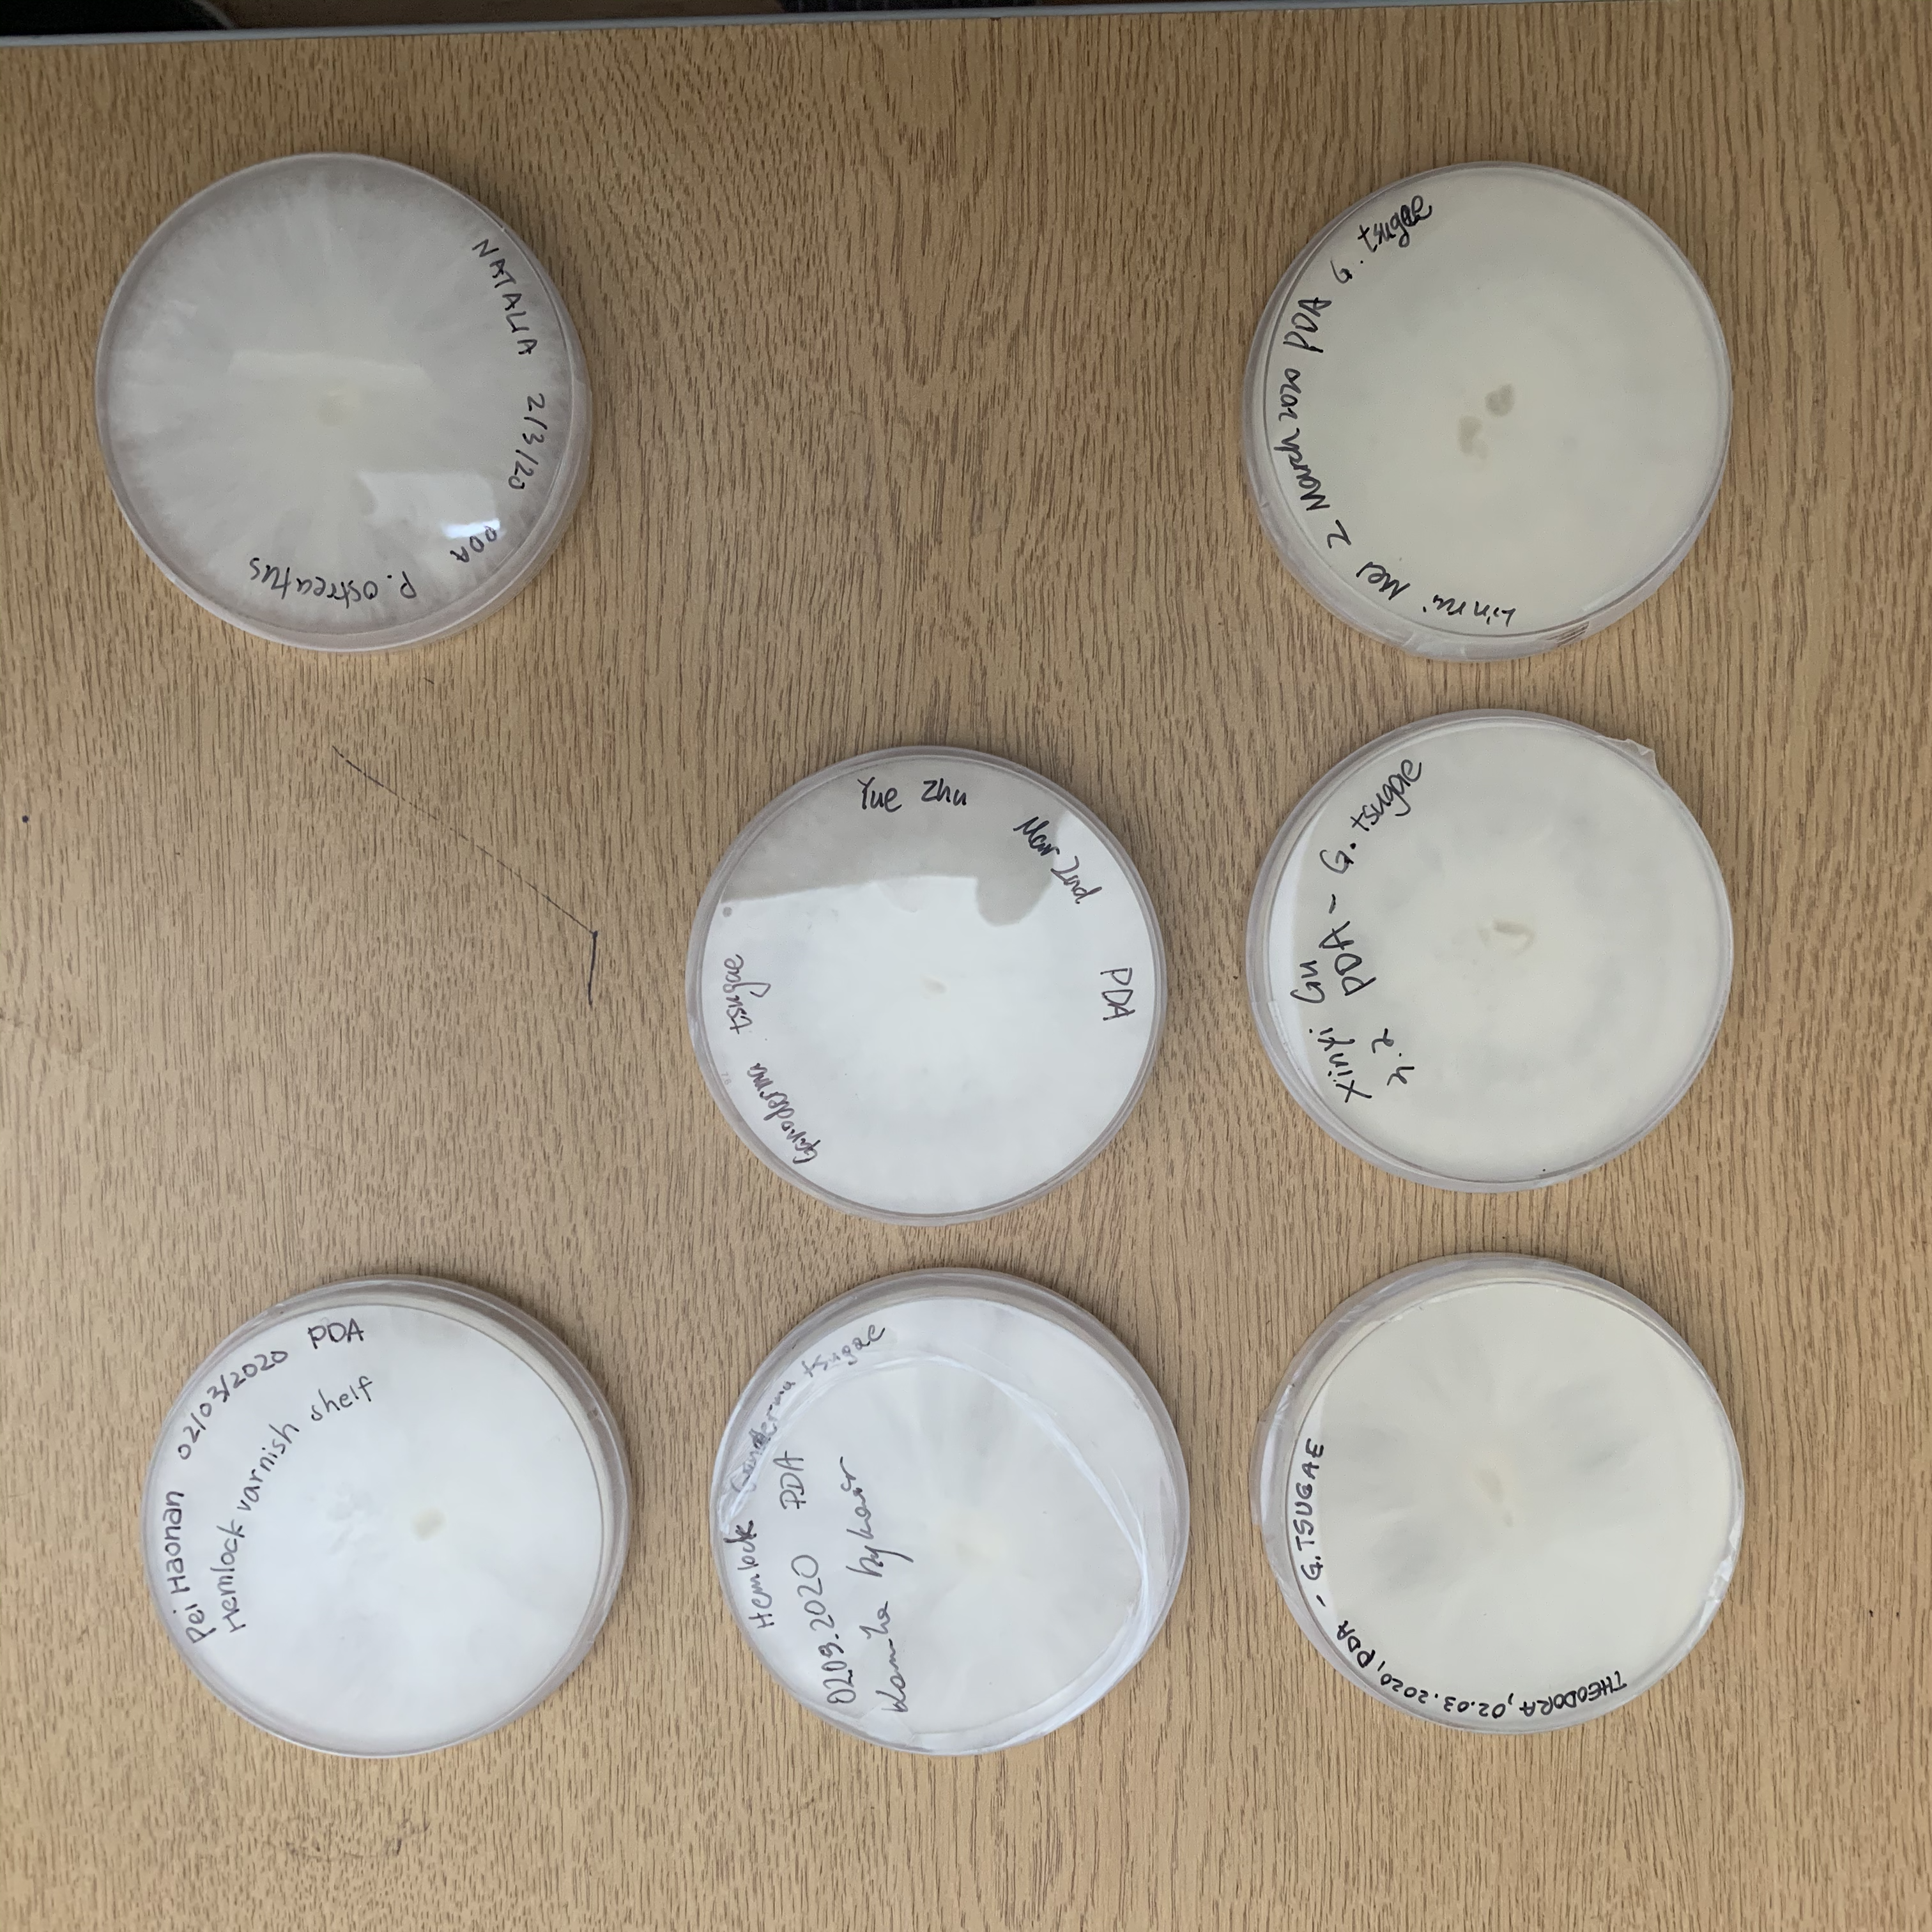

Accessible Vertical Farming (AVF)
The designer wanted to change the way how society works together to achieve sustainability goal in a specific community, the landfills in Tropical countries, as the same time, find a better way to optimise current tyres recycling process.
He wanted to bring marginalised population who lives around and relies on landfills into this ambitious sustainable plan.
He started his research by discovering the disadvantage of the current tyre recycling industry and mushroom production. After a significant load of investigation, he found a magical meet point to solve both of the problems.
When people reform used tyres into new ones, tremendous toxic waste born. When we chop used tyres up for building playground or urban infrastructure, the fragment degraded naturally and remained harmfully for creatures in the ocean at last. It is also a bad idea to store them in landfills because they remain for hundreds of years and, with their shape, tyres are hotbeds for mosquitos, bacteria and virus under warm sunshine and high humidity.
He wanted to bring marginalised population who lives around and relies on landfills into this ambitious sustainable plan.
He started his research by discovering the disadvantage of the current tyre recycling industry and mushroom production. After a significant load of investigation, he found a magical meet point to solve both of the problems.
When people reform used tyres into new ones, tremendous toxic waste born. When we chop used tyres up for building playground or urban infrastructure, the fragment degraded naturally and remained harmfully for creatures in the ocean at last. It is also a bad idea to store them in landfills because they remain for hundreds of years and, with their shape, tyres are hotbeds for mosquitos, bacteria and virus under warm sunshine and high humidity.
设计师希望改变社会共同努力的方式,以在特定社区实现可持续发展目标,热带国家的垃圾填埋场同时寻找优化当前轮胎回收过程的更好方法。
他想将生活在周围并依赖垃圾填埋场的边缘化人口纳入这个雄心勃勃的可持续计划。
他通过发现当前轮胎回收行业和蘑菇生产的劣势开始了他的研究。经过大量调查后,他找到了一个神奇的交汇点来解决这两个问题。当人们将旧轮胎改造成新轮胎时,就会产生大量有毒废物。当我们砍掉旧轮胎用于建造游乐场或城市基础设施时,碎片自然降解,最终对海洋中的生物有害。将它们储存在垃圾填埋场也是一个坏主意,因为它们可以保存数百年,而且轮胎的形状在温暖的阳光和高湿度下是蚊子、细菌和病毒的温床。
他想将生活在周围并依赖垃圾填埋场的边缘化人口纳入这个雄心勃勃的可持续计划。
他通过发现当前轮胎回收行业和蘑菇生产的劣势开始了他的研究。经过大量调查后,他找到了一个神奇的交汇点来解决这两个问题。当人们将旧轮胎改造成新轮胎时,就会产生大量有毒废物。当我们砍掉旧轮胎用于建造游乐场或城市基础设施时,碎片自然降解,最终对海洋中的生物有害。将它们储存在垃圾填埋场也是一个坏主意,因为它们可以保存数百年,而且轮胎的形状在温暖的阳光和高湿度下是蚊子、细菌和病毒的温床。

Designer faced three essential questions.Is using the inner surface of used tyres as the place to grow mushrooms a good idea?
1. With most wasted food from local London restaurant as substrate, can farmers grow mushrooms out of basements or wirehouses whos shady environment powered with energy consumption?
-Are mushrooms growing in tyres eatable?
(With local London farmers suggestion, Pei chose eight kinds of mushrooms naturally grow in the U.K for the experiment. He founded a team with friends from the biology engineering department of Imperial College. They successfully harvested mushrooms grew in recycled tyres in their yards from local garages. Later on, they did toxicity detection in Bio lab. The result is negative. But the test of “if mushroom can help degrade”)
2.How can this technology fit different environment needs in all possible district on this planet?
-How can they check “what do they need to do” or “which fungi type of growing” as a user or client?
He tried to contact people from the programme of meteorology and geography, and origin people from target place to help detect and make a user map. Unfortunately, at last, Pei just found only one set of valid data, Thailand as the place, coconut skin and shell as substrate, Chanterelle mushrooms as the fungi type. But he trusts that if here’s more time and help, he can achieve a user map
3.Why people use this technology?
-How can this technology change the way to reach sustainability goal?
Pei’s original idea of this technology is to help litter pickers who live on landfill, and then, drop them in together with the whole society, to help our living environment. As the same time, to give another option to our community to recycling used tyres, to save energy used to supervise and control the environment in current mushroom production. Finding abandoned tyres in landfills, then taking them back to communities for growing mushrooms as food, eating them or selling for money. The fact is, Childrens living on dumps have averagely $1.5 income per day, and they are taking a significant risk of the terrible living environment gives. Garbage importing countries’ government can also benefit a little bit by producing meagre cost and biodegradable substrate from wasted food, then popularise to their citizen. Another thing, the technology itself is full of educational meaning. Here are far more aspect the Accessible Vertical Farming can help
1. With most wasted food from local London restaurant as substrate, can farmers grow mushrooms out of basements or wirehouses whos shady environment powered with energy consumption?
-Are mushrooms growing in tyres eatable?
(With local London farmers suggestion, Pei chose eight kinds of mushrooms naturally grow in the U.K for the experiment. He founded a team with friends from the biology engineering department of Imperial College. They successfully harvested mushrooms grew in recycled tyres in their yards from local garages. Later on, they did toxicity detection in Bio lab. The result is negative. But the test of “if mushroom can help degrade”)
2.How can this technology fit different environment needs in all possible district on this planet?
-How can they check “what do they need to do” or “which fungi type of growing” as a user or client?
He tried to contact people from the programme of meteorology and geography, and origin people from target place to help detect and make a user map. Unfortunately, at last, Pei just found only one set of valid data, Thailand as the place, coconut skin and shell as substrate, Chanterelle mushrooms as the fungi type. But he trusts that if here’s more time and help, he can achieve a user map
3.Why people use this technology?
-How can this technology change the way to reach sustainability goal?
Pei’s original idea of this technology is to help litter pickers who live on landfill, and then, drop them in together with the whole society, to help our living environment. As the same time, to give another option to our community to recycling used tyres, to save energy used to supervise and control the environment in current mushroom production. Finding abandoned tyres in landfills, then taking them back to communities for growing mushrooms as food, eating them or selling for money. The fact is, Childrens living on dumps have averagely $1.5 income per day, and they are taking a significant risk of the terrible living environment gives. Garbage importing countries’ government can also benefit a little bit by producing meagre cost and biodegradable substrate from wasted food, then popularise to their citizen. Another thing, the technology itself is full of educational meaning. Here are far more aspect the Accessible Vertical Farming can help
设计师面临三个基本问题。
使用旧轮胎的内表面作为种植蘑菇的地方是个好主意吗?
1. 以伦敦当地餐馆的大部分废弃食物为基质,农民可以在能源消耗驱动的阴暗环境中的地下室或铁丝网中种植蘑菇吗?- 轮胎中的蘑菇可以食用吗?
在伦敦当地农民的建议下,pei选择了在英国自然生长的八种蘑菇进行实验。他与帝国理工学院生物工程系的朋友组建了一个团队,他们成功地从当地的院子里收获了用回收轮胎种植的蘑菇。车库。后来他们在生物实验室做了毒性检测。结果是阴性。但是“蘑菇是否可以帮助降解”的测试
2.这项技术如何适应地球上所有可能地区的不同环境需求?
- 作为用户或客户,他们如何检查“他们需要做什么”或“哪种真菌类型的生长”?
他尝试联系气象和地理项目的人,以及目标地点的起源人帮助检测并制作了一张用户图,可惜最后只找到了一组有效数据,以泰国为地点,以椰子皮和贝壳为基质,以鸡油菌为菌类。但他相信,如果这里有更多的时间和帮助,他可以实现一个用户图
3.为什么人们使用这项技术? - 这项技术如何改变实现可持续发展目标的方式?
我对这项技术的最初构想是帮助生活在垃圾填埋场的垃圾捡拾者,然后与整个社会一起将它们丢弃,帮助我们的生活环境。作为同时,为我们的社区提供另一种选择,回收废旧轮胎,节省能源,用于监督和控制当前蘑菇生产的环境。在垃圾填埋场找到废弃轮胎,然后将它们带回社区种植蘑菇作为食物,食用它们或者卖钱。事实是,生活在垃圾场上的儿童平均每天收入 1.5 美元,他们正在冒着可怕的生活环境带来的巨大风险。垃圾进口国政府也可以通过生产微薄的成本和来自废弃食物的可生物降解基质,然后普及到他们的公民。另外,技术本身就充满教育意义。这里有更多方面的 AVF可以提供帮助
使用旧轮胎的内表面作为种植蘑菇的地方是个好主意吗?
1. 以伦敦当地餐馆的大部分废弃食物为基质,农民可以在能源消耗驱动的阴暗环境中的地下室或铁丝网中种植蘑菇吗?- 轮胎中的蘑菇可以食用吗?
在伦敦当地农民的建议下,pei选择了在英国自然生长的八种蘑菇进行实验。他与帝国理工学院生物工程系的朋友组建了一个团队,他们成功地从当地的院子里收获了用回收轮胎种植的蘑菇。车库。后来他们在生物实验室做了毒性检测。结果是阴性。但是“蘑菇是否可以帮助降解”的测试
2.这项技术如何适应地球上所有可能地区的不同环境需求?
- 作为用户或客户,他们如何检查“他们需要做什么”或“哪种真菌类型的生长”?
他尝试联系气象和地理项目的人,以及目标地点的起源人帮助检测并制作了一张用户图,可惜最后只找到了一组有效数据,以泰国为地点,以椰子皮和贝壳为基质,以鸡油菌为菌类。但他相信,如果这里有更多的时间和帮助,他可以实现一个用户图
3.为什么人们使用这项技术? - 这项技术如何改变实现可持续发展目标的方式?
我对这项技术的最初构想是帮助生活在垃圾填埋场的垃圾捡拾者,然后与整个社会一起将它们丢弃,帮助我们的生活环境。作为同时,为我们的社区提供另一种选择,回收废旧轮胎,节省能源,用于监督和控制当前蘑菇生产的环境。在垃圾填埋场找到废弃轮胎,然后将它们带回社区种植蘑菇作为食物,食用它们或者卖钱。事实是,生活在垃圾场上的儿童平均每天收入 1.5 美元,他们正在冒着可怕的生活环境带来的巨大风险。垃圾进口国政府也可以通过生产微薄的成本和来自废弃食物的可生物降解基质,然后普及到他们的公民。另外,技术本身就充满教育意义。这里有更多方面的 AVF可以提供帮助
The piccture attached below is the stakeholder map 👇

Pics about the process


︎︎︎1
2︎︎︎
︎︎︎3
4︎︎︎
︎︎︎5
6︎︎︎
2︎︎︎
︎︎︎3
4︎︎︎
︎︎︎5
6︎︎︎